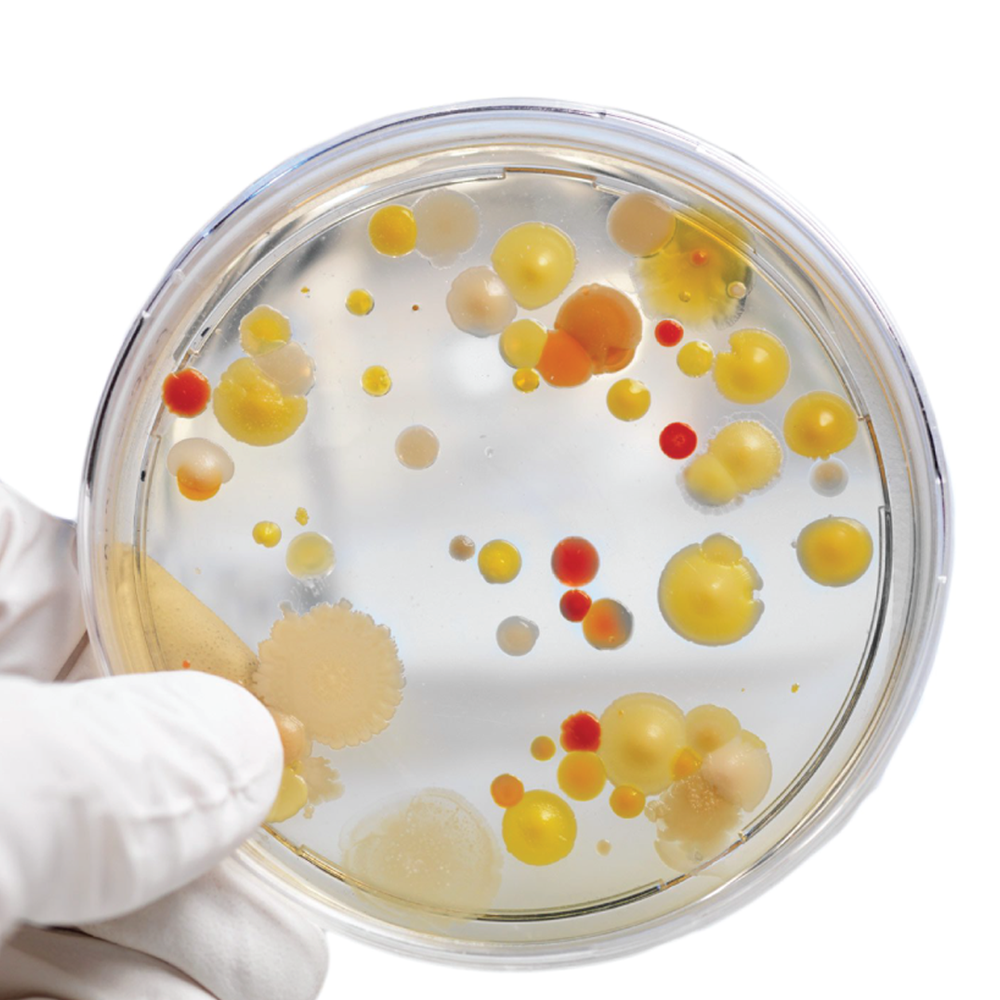
Picture for category Microbiology

Welcome to the ProSource Scientific Website
Your professional
lab & science
supply partner
lab & science
supply partner
ProSource Scientific is a 100% Canadian-owned laboratory supplier with over 20 years of experience in the Canadian scientific marketplace.

Autosampler Vial Convenience Kits
PSChrome 2ml Glass Autosampler Vials with pre-slit blue PTFE/white silicone septa. Vials and caps packaged separately in a clam shell Convenience Kit. Always in stock. Volume discounts available.
From $45.00

Whirl-Pak Bags
Whirl-Pak Bags are strong, sterile, and leak-proof. Made of polyethylene, they are designed to carry solids or liquids to a laboratory for testing. Sterile sampling you can rely on. Always in stock.
From $104.92

Top Quality Phoenix 100 x 15mm Petri Dishes
Top quality Phoenix 100 x 15 mm Sterile Semi-Stackable Petri Dishes for both manual pouring and automated pouring equipment. Semi-stacking with 3 vents and ISO mark. Always in stock.
$144.62
Featured Products
The best and latest equipment, hand-picked by our team
Explore Our Products
All of our online product categories can be seen below - scroll further to see our other services!
Chemicals
ProSource Scientific brings you a large selection of superior quality chemicals and solutions, produced specifically for use in laboratories and manufacturing.

Anything we can help with?
You've got questions, we've got answers.
Reach out and let's see what we can do together.